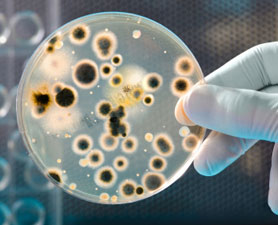
image053.jpg image053.jpg

Метастазы Мексиканского залива
Желающие могут также ознакомиться со статьёй «В объятиях сумасшедших учёных: Рутинные дела Монсанто, Форта Деррик и Атлас Венчур», описывающий историю разработок биологического оружия в США. Тема биологического оружия в американских условиях подробно обсуждалась в ходе беседы с д-ром Биллом Диглом. Её содержание близко к тематике бесед исследователя Майкла Эдварда с руководителем информационного портала Джеффом Рензе (http://www.rense.com/). Ещё более широкий взгляд на вещи, происходящие в здравоохранении и экологии, можно получить из (переведённого на русский язык) интереснейшего интервью финского д-ра Рауни-Лиина Лууканен Кильде (коллеги нашего главсанврача Онищенко). [10] Весьма рекомендуется: части 1, 2, 3, 4, 5, 6, 7.
Длительное расследование по теме Синей чумы группой анонимных учёных, фронтменом которых выступает американский отставной офицер Майкл Эдвард, нашло полное понимание и подтверждение в нескольких недавних выступлениях доктора биологических наук, академика П.П. Гаряева (включая принцип создания и действия Синей чумы, а также наиболее эффективный способ борьбы с ней). В его интерпретации речь также идёт о применении биологического оружия в региональном и планетарном масштабе.
Фотография колоний нефтеядных бактерий - http://news.discovery.com/tech/oil-eating-microbes-gulf-oil-spill.html.
Напомню, что первый искусственный организм, созданный человеком, предназначался именно для поедания нефти. То, что выведенный на его основе организм приспособится поедать и другие живые организмы, видимо в расчёт не принималось (или принималось?).



Важная информация о наркотиках - наркоманам на заметку. В Нью-Йорке и Лос-Анжелесе к конечным потребителям поступает необычный кокаин. Ситуация получила огласку после того, как было замечено, что 8-9-летние школьники, придя в школу, раздавали наркотик своим сверстникам. Этот кокаин оказался смешанным с ветеринарным препаратом левамизолом, [11] который у человека может вызывать инфекцию, аналогичную МРЗС, [12] и приводить к некрозу мягких тканей и даже гибели. Так что наркотический «торч» у кокаинщиков сменялся почернением конечностей и даже быстрой смертью.
Д-р Линди Фокс из Университета штата Калифорния отметила, что реакция на левамизол бывает различной, и уточнила, что ей известны случаи, когда вся поверхность тела пациентов, включая лицо, начинала мертветь и становилась чёрной. Поверхность зон омертвения в считанные дни вызывала иммунную реакцию, которая практически блокировала кровоток в поражённых участках тела. Без притока крови клетки массово отмирают, за чем следует хирургическое удаление мягких тканей, и даже заражение крови.
Дополнительной проблемой является то, что левамизол блокирует выработку спинным мозгом белых кровяных телец, которые борются с инфекцией. Автор публикации, Александр Хиггинс отмечает, что такого кокаина в общей массе его поставок 82%. Д-р Ной Крэфт, дерматолог из биомедицинского исследовательского института Лос-Анжелеса описывает симптоматику, наблюдающуюся у шести потребителей наркотика, заболевшей этой кокаиновой чумой и подчёркивает национальные масштабы этой напасти: «Важно, чтобы граждане знали, что это касается не только Нью-Йорка и Лос-Анжелеса. Это содержится во всём кокаине, поставляемом в США». То есть, и богатый и бедный в данном случае равны…


По данным Центра по контролю и профилактике заболеваний (CDC), в этом году на востоке, западе и юге США отмечается необычная эпидемия лисьего бешенства. Агрессивные рыжие лисицы нападают на детей и взрослых. Отбиться от них подручными предметами удавалось с большим трудом; много людей оказалось искусанными больными животными. Научная статья, демонстрируемая в видеоролике, связывает данное явление с вирусом H5N1 (механизм простой: хищники поедают трупы птиц и заражаются буйным бешенством). Как видно из карты, наибольшее число лисиц с бешенством зарегистрировано на востоке Америки (в самой густонаселённой части страны), в зоне доминирующих ветров.
Для чего этот факт упомянут? Дело в том, что на сайте «National Geographic» опубликована статья о болезни, которая может превращать в зомби уже людей. Если бы не престижный сайт, от такого бреда сразу можно было бы отмахнуться. Но похожий материал появился и на сайте Центра по контролю и профилактике заболеваний США (CDC). О чём эти статьи? Саманта Андреански, вирусолог из Университета Майами сообщает о способах, которые могут привести к мутации вируса бешенства у животных (ультрафиолет, ошибки в процессе репликации, [и лабораторные разработки, конечно]), в результате чего он начнёт проявляться у человека не через 10 дней или год, а через час-два. Бешенство, если его не лечить, приводит к смерти в течение недели. Типичные симптомы этого заболевания – беспокойство, растерянность, галлюцинации и паралич – это меньшее из того, что ожидает заражённых людей. [Конечно же, сюжет фильма/компьютерной игры «Обитель зла» - первое, что приходит на ум после таких публикаций.]
С. Андреански рассматривает вариант комбинации вируса бешенства и гриппа, распространяющегося воздушно-капельным путём, и отмечает, что генетические изменения у вирусов – это один из способов разрушения защитных механизмов и барьеров организмов, в которых они развиваются. То есть, вирусы только этим и занимаются; это их образ жизни. О том, что «скоротечный» вариант заболевания лисиц, летучих мышей и скунсов бешенством уже обнаружен и активно распространяется среди животных этих видов, сообщалось в ещё одной более ранней публикации в «National Geographic» (в 2009 г.). И вероятность мутации такого вируса в вирус, передаваемый от человека к человеку, обсуждалась уже тогда. Молекулярный вирусолог из медицинского института при Университете Эмори в Атланте, Хинх Ли заявил, что риск появления штамма бешенства, передаваемого человеком «должен вызывать большую обеспокоенность». Фактором, способствующим мутациям вируса, является проживание скунсов и летучих мышей по соседству с людьми. В качестве меры предосторожности среди домашних собак Аризоны был установлен 3-месячный карантин.


Не будем забывать также, что монтокских монстров (фото слева) неоднократно находили поблизости от секретных биолабораторий США (о. Плам-айленд недалеко от Нью-Йорка). С учётом работы лабораторий других стран перспективы встретить в своём уютном дворике «нечто» обретают реальные черты.
В статье на официальном сайте Центра по контролю и профилактике заболеваний США «Готовность 101: Апокалипсис зомби» рассматриваются корни темы зомби в массовой культуре и данные на тему причин их вероятного появления, включая прионов [13] и мутацию вирусов, вызывающих бешенство и корь. Эта заметка сопровождается картинкой с логотипом CDC и призывом: «Сделай запас. Составь план. Будь готов» (см. изображение справа вверху). Обращает на себя внимание следующий её фрагмент.
«Что же следует сделать до того как зомби, ураганы или пандемия действительно нагрянут к вам? Прежде всего, у вас дома должен иметься аварийный комплект на случай ЧС. В него должны входить вода, продукты питания и прочие запасы, которые помогут вам продержаться первые несколько дней, пока не доберётесь до лагеря для беженцев, защищённого от зомби (или в случае природной катастрофы даст вам время на то, чтобы достичь эвакуационного центра или дождаться восстановления сети подземных коммуникаций). Вот что ваш аварийный комплект должен включать (полный перечень см. на страничке, посвящённой чрезвычайным ситуациям).
- Воду (примерно по 3л на человека в сутки)
- Запас продуктов (долгого хранения)
- Медикаменты и лекарства (как специальные, так и общего назначения)
- Бытовые принадлежности и инструменты (бытовой нож, клейкую ленту, приёмник с запасом батареек и т.п.)
- Предметы гигиены (хозяйственный отбеливатель, мыло, полотенца и пр.)
- Одежду и постельные принадлежности (смену одежды на каждого члена семьи, комплекты белья и т.п.)
- Важные документы (копии паспорта, водительского удостоверения, свидетельства о рождении и т.д.)
- Аптечку первой помощи (если вас укусит зомби, она не поможет, но пригодится для обработки обычных порезов и ран, которые можно получить во время торнадо или урагана).
Подготовив аварийный комплект, соберите свою семью и выработайте план по действиям в условиях чрезвычайной ситуации. Например, куда вы направитесь, и кого будете звать, если у вас на пороге появятся зомби. Этот же план пригодится вам и в случае наводнения, землетрясения и иных ЧС. Выберите место встречи членов семьи (например, возле почтового ящика). Наметьте два места для встречи: одно поблизости от вашего дома, другое – далеко». Вы что-то подобное на сайте нашего МЧС или правительства читали?]
Тема зомби выглядела бы каким-то психологическим приёмом, рассчитанным на массового читателя, если бы не было оснований ожидать возникновения реальной эпидемии, которая сделает часть населения «неадекватной».
Столь же странная публикация появилось в начале июня и на официальном сайте НАСА: два видеообращения к сотрудникам этой организации и членам их семей с призывом выработать план действий по спасению своих близких (включая домашних питомцев) в условиях чрезвычайной ситуации, «аналогичной событиям 11 сентября [2001]». Общий тон обращения такой же: «будьте готовы!». Перечень предметов и тематика примерно тот же, что и выше (только без зомби), и включает: способы жизнеобеспечения, поддержания связи, назначения мест возможных встреч и т.д. Рекомендуется создать дома запас воды, пищи, топлива, одежды и всего, что необходимо в случае чрезвычайной ситуации. Вероятно, штат сотрудников аэрокосмической отрасли, представляющий собой «ценный ресурс человеческого капитала», безусловно, удостоили внимания Хозяев, пытающихся сберечь свои «активы» в условиях грядущей американской катастрофы? Между прочим, Минобороны до сих пор продолжает активные мероприятия, основанные на событиях аналогичных урагану Катрина. Сообщения о совместных действиях различных группировок войск (с привлечением и российского корабля Адмирал Чабаненко) этими весной-летом не сходят с новостных лент.
Применение химико-биологической войны через распыление в атмосфере необычных биоматериалов и реагентов (явление так называемых химтрейлов) продолжается и в Штатах, и в России. Порталы, содержащие сотни научных и любительских публикаций, снимков и отчётов на эту тему множатся.
Вот статистика наблюдений одной из групп наблюдателей:
http://groups.yahoo.com/group/chemtrailtrackingusa/
Некоторые исследования и массивы данных по этой тематике:
http://www.carnicom.com/
http://imageevent.com/firesat/strangedaysstrangeskies
http://www.bariumblues.com/
http://www.rense.com/Datapages/morgdat1.htm
http://www.rense.com/politics6/chemdatapage.html
А вот химтрейлы, видимые из космоса:
http://www.rense.com/general3/massive.htm
http://www.rense.com/general32/sat.htm
http://www.rense.com/general11/morechm.htm
http://www.rense.com/general4/chmgb.htm
Имеется немало свидетельств тому, что химтрейлы (помимо химическо-биологического аспекта) являются компонентом системы HAARP и её более новых (мобильных) систем направленного геофизического воздействия.

Химтрейлы на закате, биокомпоненты из химтрейла среди клеток крови и внешние признаки болезни моргеллонов.
Для владеющих английским настоятельно рекомендуется обстоятельный рассказ на тему химтрейлов основателя калифорнийской программы «Skywatch» («Небесный дозор»), специалиста по проблемам сельского хозяйства Розалинды Питерсон. Взвешенный и сугубо научный взгляд на проблему «воздушного геноцида» в масштабах всей планеты. К изучению химтрейлов Питерсон пришла через исследование причин снижения продуктивности различных сельхозкультур, которая обозначилась в 1989 году. В поиске ответов на возникавшие вопросы, она в 2000 году обратила внимание на странные следы в небе…
[10] - В недалёком прошлом - главный врач-специалист Лапландии по трём медицинским специальностям, и.о. директора по Экологическому и Медицинскому Образованию Финляндии, зам. главного врача Финляндии на Национальном Совете Здравоохранения Финляндии.
[11] - глистогонное средство для крупнорогатого скота, овец и свиней.
[12] - метициллин-резистентный золотистый стафилококк; смертельно опасное заболевание, вызывающее некроз тканей.
[13] - прионы - возбудители некоторых нейродегенеративных заболеваний человека и животных; инфекционная болезнь, виновником которой является белок приона.

